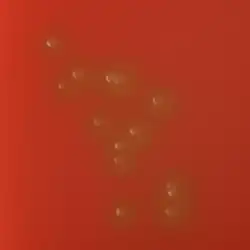

Кровяной агар
Кровяной агар — обобщённое название питательных сред, содержащих в составе кровь животных. Предназначен для выделения и культивирования прихотливых микроорганизмов, а также их первичной дифференциации по типу гемолиза.
Состав и приготовление
Кровяной агар готовят путём добавления к расплавленной и охлаждённой до 45-50 °C стерильной плотной питательной среде от 5 до 10 % крови животных. В отличие от шоколадного агара, кровь не подвергают нагреванию с целью лизировать эритроциты, в связи с этим, можно считать кровяной агар первичной средой по отношению к шоколадному агару.
В качестве агаризованной питательной среды при приготовлении кровяного агара могут быть использованы:
- колумбийский агар (Columbia agar),
- агар для бруцелл,
- эритрит-агар,
- агар Гивенталя-Ведьминой (АГВ),
- триптиказо-соевый агар (trypticase soy agar),
- сердечно-мозговой агар (brain heart infusion agar)
Наиболее часто для приготовления кровяного агара используют дефибринированную баранью кровь. В зависимости от назначения среды и выделяемых микроорганизмов, могут использовать кровь и других животных, например, лошадиную, крупного рогатого скота (кровь КРС), кроличью, морских свинок. Человеческую (донорскую) кровь не рекомендуют для приготовления кровяного агара из-за того, что она может содержать антитела, подавляющие рост бактерий[3].
Гемолиз, вызываемый микроорганизмами на кровяном агаре

В результате метаболической активности некоторые микроорганизмы выделяют различные экзотоксины (гемолизины), вызывающие лизис крови (гемолиз). Особенностью кровяного агара является возможность наблюдать гемолитическую активность микроорганизмов и дифференцировать их по типу гемолиза. Гемолиз разделяют на три типа:
- α-гемолиз (альфа-гемолиз) — происходит частичное разрушение эритроцитов с сохранением клеточной стромы, в ходе этого типа гемолиза гемоглобин превращается в метгемоглобин, за счёт чего питательная среда в зоне роста бактерий приобретает зеленоватый оттенок. Наиболее часто α-гемолиз вызывают зеленящие стрептококки.
- β-гемолиз (бета-гемолиз) — полный лизис эритроцитов, при котором в зоне роста микроорганизма питательная среда обесцвечивается. Такой тип гемолиза характерен для стафилококков, бета-гемолизирующих стрептококков, листерий, клостридий и некоторых других микроорганизмов.
- γ-гемолиз (гамма-гемолиз) — отсутствие гемолиза, цвет кровяного агара в зоне роста микроорганизма остаётся неизменным[4].
У некоторых микроорганизмов тип гемолиза может изменяться под воздействием условий окружающей среды. Например, пневмококк при культивировании в присутствии кислорода образует на кровяном агаре зоны α-гемолиза, однако под воздействием некоторых антибиотиков или при культивировании в анаэробных условиях происходит β-гемолиз[5]. Clostridium perfringens и некоторые другие микроорганизмы могут образовывать двойные зоны гемолиза[6].
Применение
Кровяной агар является одной из питательных сред, которая в обязательном порядке применяется при диагностических исследованиях клинического материала[7].
Кровяной агар, приготовленный на основе агара Мюллера-Хинтон с добавлением 5 % дефибринированной лошадиной крови и 20 мг/л НАД, применяют для определения чувствительности к антибактериальным препаратам бактерий со сложными питательными потребностями, например, стрептококков групп A, B, C и G, Streptococcus pneumoniae, Haemophilus influenzae, Moraxella catarrhalis и др[8].
См. также
Примечания
- ↑ МУК 4.2.1887—04 Лабораторная диагностика менингококковой инфекции и гнойных бактериальных ме-нингитов. rospotrebnadzor.ru. Дата обращения: 7 апреля 2017. Архивировано 1 апреля 2017 года.
- ↑ Atlas, Ronald M., 1946-. Handbook of microbiological media. — Taylor & Francis, 2010-01-01. — ISBN 9781439804087.
- ↑ WHO Centers for Disease Control and Prevention (U.S.). Laboratory methods for the diagnosis of meningitis caused by neisseria meningitidis, streptococcus pneumoniae, and haemophilus influenzae : WHO manual. — 2. — 2011. — 323 с.
- ↑ Einar Leifson. Types of Bacteria on Blood and Chocolate Agar and the Immediate Cause of These Types // Journal of Bacteriology. — 1932. — Т. 24, вып. 6. — С. 473–487. — ISSN 0021-9193.
- ↑ Victor Lorian, Bodun Popoola. Pneumococci Producing Beta Hemolysis on Agar (англ.) // Applied Microbiology. — 1972-07-01. — Vol. 24, iss. 1. — P. 44–47. — ISSN 0099-2240. Архивировано 6 декабря 2020 года.
- ↑ Медицинская микробиология. — М., 1998. — 1200 с. — ISBN 5-88816-048-2.
- ↑ Приказ МИНЗДРАВА СССР ОТ 22.04.85 N 535 Об унификации микробиологических (бактериологических) методов исследования, применяемых в клинико-диагностических лабораториях лечебно-профилактических учреждений. lawrussia.ru. Дата обращения: 13 апреля 2017. Архивировано 4 мая 2017 года.
- ↑ Определение чувствительности микроорганизмов к антимикробным препаратам: клинические рекомендации. — 2015. Архивировано 18 ноября 2016 года.